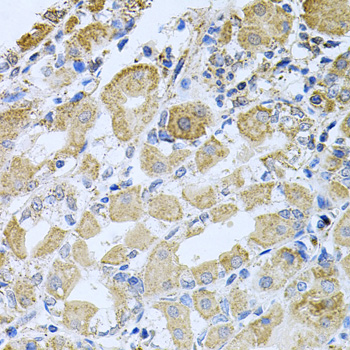
产品细节图片1

相关产品推荐更多 >
万千商家帮你免费找货
0 人在求购买到急需产品
- 详细信息
- 文献和实验
- 技术资料
- 免疫原:
Recombinant protein of human BCR
- 亚型:
IgG
- 形态:
液体/冻干粉
- 保存条件:
Store at -20°C. Avoid freeze / thaw cycles.
- 克隆性:
多克隆
- 标记物:
Biotin,Cy3,Cy3.5,Cy5,Cy5.5,Cy7,FITC,HRP,RBITC,SAlexa Fluor 350,SAlexa Fluor 405,SAlexa Fluor 488,SAlexa Fluor 532,SAlexa Fluor 555,SAlexa Fluor 568,SAlexa Fluor 594,SAlexa Fluor 633,SAlexa Fluor 640,SAlexa Fluor 647,SAlexa Fluor 660,SAlexa Fluor 680,SAlexa Fluor 750
- 适应物种:
Human Mouse Rat
- 保质期:
1-3年
- 抗原来源:
Recombinant protein of human BCR
- 目录编号:
613
- 级别:
科研级别
- 库存:
888
- 供应商:
北京索莱宝科技有限公司
- 宿主:
Rabbit
- 应用范围:
WB IHC
- 浓度:
WB 1:500-2000. IHC 1:50-100.
- 靶点:
BCR
- 抗体英文名:
Anti-BCR Polyclonal Antibody
- 抗体名:
Bcr抗体
- 规格:
50ul/100ul
| 规格: | 50ul | 产品价格: | ¥960.0 |
|---|---|---|---|
| 规格: | 100ul | 产品价格: | ¥1600.0 |
A reciprocal translocation between chromosomes 22 and 9 produces the Philadelphia chromosome, which is often found in patients with chronic myelogenous leukemia. The chromosome 22 breakpoint for this translocation is located within the BCR gene. The translocation produces a fusion protein which is encoded by sequence from both BCR and ABL, the gene at the chromosome 9 breakpoint. Although the BCR-ABL fusion protein has been extensively studied, the function of the normal BCR gene product is not clear. The protein has serine/threonine kinase activity and is a GTPase-activating protein for p21rac. Two transcript variants encoding different isoforms have been found for this gene.
风险提示:丁香通仅作为第三方平台,为商家信息发布提供平台空间。用户咨询产品时请注意保护个人信息及财产安全,合理判断,谨慎选购商品,商家和用户对交易行为负责。对于医疗器械类产品,请先查证核实企业经营资质和医疗器械产品注册证情况。
 文献和实验
文献和实验Polyclonal Antibody Production
, if desired this is best accomplished by Protein A Affinity Chromatography. 上一篇:make an Antibody against a Peptides 下一篇:Immunization Protocol for Monoclonal Antibody Production
Polyclonal Antibody Production
Polyclonal Antibody Production Very useful for rapid and simple generation of antibodies for western blots, ELISA assays, and immunoprecipitation. Rabbit Immunization Initial Preparation Your antigen
a simple ELISA method to detect human anti-antibody response.










